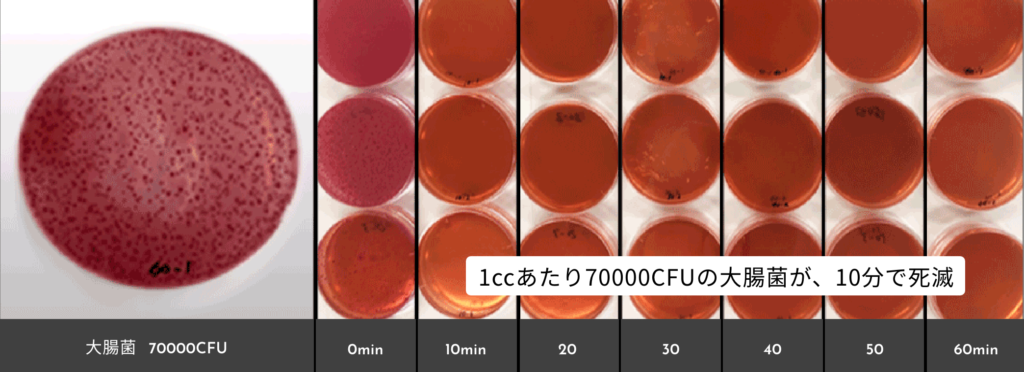

目次
「体をゴシゴシ洗う手間」を引き算。大人のバスタイムは“頑張らない”が正解
仕事に家事、育児。ノンストップで駆け抜けた一日の終わり、ようやくたどり着いたバスルームで「あぁ、これから全身洗わなきゃ……」と、お風呂に入ることさえ「TODOリスト」の一つのように感じてしまう夜はありませんか?
本来、お風呂は一日で一番自分を甘やかしていい時間のはず。だからこそ、忙しい私たちに今必要なのは、「洗う」という手間を思い切って引き算する新習慣です。
それを叶えてくれるのが、サイエンスのマイクロバブル入浴装置「ミラバス」。浴槽に設置するだけで、微細な水と空気だけの気泡で満たされ、ただゆったりと浸かっているだけで気泡が全身の汚れを優しく落としてくれるのです。
この「洗わない(洗われる)贅沢」は、単なる美容の枠を超え、今や心強いインフラとして、忙しい私たちの肌と心を支えているのです。
【CM動画でチェック!】ミラバスが叶える入浴体験
試験日:2019年9月26日
試験方法:皮膚上にアイライナー、口紅、靴用クリーム、油性ペンを塗布し、
マイクロバブル入浴装置「ミラバス」を使用した浴槽に10分間入浴。入浴前後の汚れの状態を比較
お湯が白く見えるのは「微細な気泡」で満たされているからでスー。浸かるだけでキレイになるでス~!
万博で大盛況! 満足度98.3%の「技術」を自宅に招くという選択
昨年の万博の大阪ヘルスケアパビリオンに展示された「ミライ人間洗濯機」はこの「座っているだけで身体が洗われる」という画期的な体験で、社会現象ともいえる大きな話題を呼びました。
驚くべきはその反響です。実際に体験した方々へのアンケートでは、満足度98.3%という数字を記録。

半信半疑の方も多かったはずですが、「肌はすべすべ。クリーム不要だった」「思った以上にリラックス効果が高かった」と、その洗浄力と心地よさに大満足の声をいただきました。
実はこの技術の原点は、1970年の大阪万博で創業者が目にした「人間洗濯機」への憧れだったんです。50年以上の時を経て結実したこの先端技術は、万博会場だけでなく、すでに「ミラバス」として私たちの自宅へ招き入れることができるようになっているんですよ。
万博会場での感動を、毎日おうちで独り占めできるとしたら最高のご褒美でスー
【基本のキ】ただの泡風呂とはワケが違う。ミラバスが誇る“3つの神機能”
①汚れを吸着して浮かす「マイクロバブル」
1ccに約数万個という微細な泡が、毛穴の奥まで入り込みます。プラスの性質を持つ皮脂汚れをマイナスの泡がしっかり吸着し、浮かせて落とします。タオルでゴシゴシ擦る必要がないため、乾燥しやすくデリケートな大人の肌を優しく守り抜きます。

試験日:2019年9月26日
試験方法:皮膚上にアイライナー、口紅、靴用クリーム、油性ペンを塗布し、
マイクロバブル入浴装置「ミラバス」を使用した浴槽に10分間入浴。入浴前後の汚れの状態を比較
より小さいウルトラファインバブルのほうが効果が出るのでは?」と思ったら大間違い。汚れを“落とす”という観点では、重要なのは泡の小ささだけではありません。大きさごとに違う気泡の特性を理解し、その気泡を効果的に発生させることが鍵となります。
マイクロバブルは汚れに吸着し、気泡の浮力で浮かせて汚れを落とすため、水流がない湯舟でただ浸かっているだけで汚れを落とすことができます。
一方、ウルトラファインバブルは、マイクロバブルと比べて、壊れにくい特徴があるため、シャワーで水流に乗せて使用していますが、水流のない湯舟に発生させても小さすぎて汚れを浮かび上がらせるほどの浮力がありません。
サイエンスは、ファインバブル専業メーカーとして培ってきた技術をもとに、目的に応じて泡の特性を選択。ミラバスでは、洗浄に適した「マイクロバブル」を採用しています。
このほかにも、ミラバスには毎日の「キレイ」を支えるさまざまな機能が備わっています。
②至福のプライベートスパ「ゆらぎ浴&スポットケア」
スクリュー状の対流が全身を包み込む「ゆらぎ浴」は、心身の緊張を解きほぐします。さらに、気になる部分をピンポイントでケアする「スポットケア」を使えば、自宅にいながらワンランク上の満足感を得られそうです。


③浴槽掃除も自動! 「マイクロイオニー」
多くのユーザーが「手放せない!」と語るのが、ボタン一つで浴槽内の汚れや菌を分解・除菌する機能。毎日の「名もなき家事」であるお風呂掃除の手間を大幅に減らしてくれます。(※ビルトイン型に搭載)
1cc当たり約70,000CFU※1の大腸菌に、マイクロバブル化した低温プラズマ発生体「マイクロイオニー」を与えた実験では、約10分後にはすべてほぼすべての大腸菌が除菌するというされる結果に。
つまり、安心感と共に浴槽のゴシゴシ掃除から解放されるということ。忙しい毎日に、時間と心のゆとりが生まれますね。
※すべての菌を除菌するわけではありません
※1:CFU(Colony forming unit)=コロニー形成単位。まいた微生物中に含まれる増殖可能な微生物細胞の数を示す単位として用いられる
自分を洗うのも、浴槽を洗うのも自動なんて「神機能」でス~!
ライフスタイルに合わせて選べる2つのミラバス—現場のプロが認めた信頼の形
ミラバスは単なる家庭用機器ではありません。すでに多くの住宅や施設で「暮らしの質」を支えるインフラとして導入されています。
・「ミラバス」(ビルトイン型)——住まいの質を高める標準装備へ

「自分をケアする時間がない」「毎日の浴槽掃除が負担」という忙しい世代に。
既存の浴槽への後施工も可能。浴室の美観を損なわず「マイクロイオニー」も使えるフル機能モデル。
※後施工不可な一部浴槽や住居もあります。
・「どこでもミラバス」——工事不要。被災地の心身も支える、ポータブルな信頼

「賃貸だから工事ができない」「今の浴槽のまま手軽に導入したい」という方に。届いたその日から使えるポータブル仕様で、住環境を問わずマイクロバブル浴を叶えます。
【ココで実装!】震災時の避難所での入浴支援(被災地用大浴場キット)にも活用。持ち運びができるため、過酷な環境でも多くの人を癒やします。
避難所にも活用されている技術だから安心感が違うでスー!
ミラバスで、お風呂を「作業」から「自分をほどく時間」へ
肌や髪をきれいにするために「何かを頑張って足す」のではなく、あえてミラバスに身を委ねて「何もしない」贅沢を選ぶ。
サイエンスが長年かけて磨き上げた「泡の技術」は、単なる贅沢品ではなく、一生を自分らしく過ごすための心強い味方です。義務だったお風呂を、自分をほどく時間へ。ミラバスが叶える「ご自愛な日常」を、今すぐはじめてみませんか?





